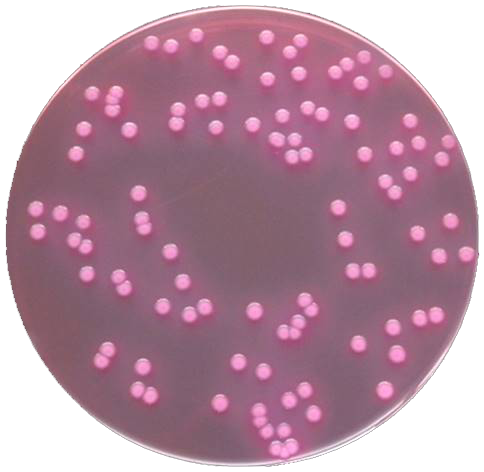

GB4789-3-2016大肠菌群计数培养基原理解析
发布时间:2020-09-04 浏览次数:5483
一、GB4789.3-2016大肠菌群MPN法培养基原理解析
•月桂基硫酸盐能抑制革兰氏阳性菌生长,胰蛋白胨提供碳源和氮源满足细菌生长的需求;氯化钠可维持均衡的渗透压;乳糖是大肠菌群可发酵的糖类;磷酸二氢钾和磷酸氢二钾是缓冲剂。
•36 ±1 ℃培养24h后若已产气,则可停止培养。如果没有观察到有产气的现象,则继续培养至48 ±2h。
•如接种量超过1mL,则用双料LST肉汤培养基。

- +
•胆盐与煌绿均能抑制革兰氏阳性菌生长。
•培养基配方当中含有胆盐,大肠菌群发酵乳糖所产的酸会与胆盐发生反应,形成胆酸沉淀。培养基可由原来的绿色变为黄色。

阴性 阳性
二、GB4789.3-2016 大肠菌群计数平板法培养基原理解析
•配方中胆盐和结晶紫抑制革兰氏阳性菌,中性红作为指示剂,在酸性条件下为紫红色。
•大肠菌群分解乳糖所产的酸与胆盐结合,可形成粉红色菌落菌落周围有胆酸盐沉淀环。
•该培养基无需高温高压灭菌,现配现用。
大肠埃希氏菌ATCC25922在VRBA上的菌落形态
更多内容请查看食品微生物检验GB4789.3-2016大肠菌群计数及注意事项。





